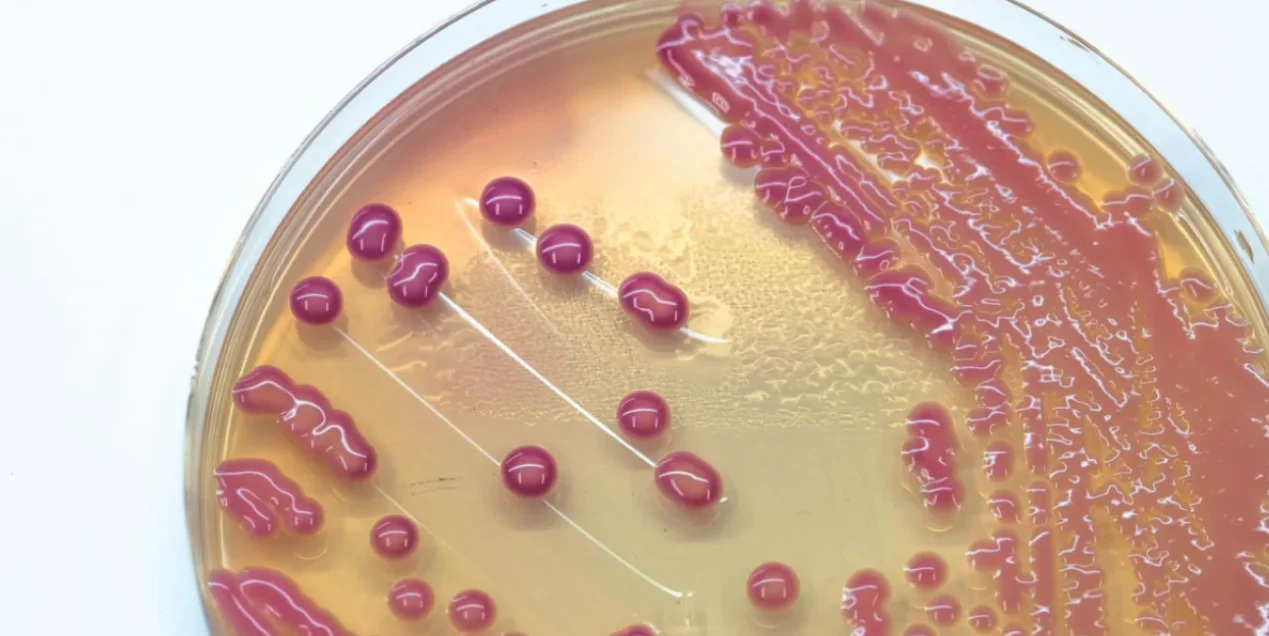

Introduction
Over 40,000 families worldwide have so far opted to bank stem cells to protect their children and families from life-threatening yet treatable conditions. However, there are still several misconceptions and stem cell banking myths. This is largely due to limited public awareness about the process, mixed messages from commercial marketing and the complex nature of stem cell science.
However, without evidence-based communication from medical experts, misconceptions continue to circulate, confusing many parents-to-be. Let’s debunk the most common myths in this informative blog!
Understanding Stem Cell Banking: A Quick Primer
Before we dispel misconceptions about stem cell banking, it is imperative to understand the basics– the what, why and how of this procedure.
- Stem cell banking is an advanced procedure that involves the collection, processing, and storage of stem cells for potential future medical use.
- Stem cells are powerful cells with the ability to differentiate into different cells in the body. These cells can be sourced from umbilical cord blood (rich in hematopoietic stem cells), cord tissue and placenta (sources of mesenchymal stem cells), bone marrow, and peripheral blood.
- Each source offers unique therapeutic possibilities, with cord-derived cells often preferred for their purity and ease of collection.
Today, stem cell therapies are successfully being used in the treatment of over 80 diseases, including leukaemia, thalassemia, and various immune disorders. At the same time, there is ongoing research to unlock the regenerative potential of stem cells for other life-threatening conditions, such as heart damage, type 1 diabetes, and neurodegenerative diseases like Parkinson’s and Alzheimer’s.
The safety and effectiveness of stem cell therapies are largely dependent on the process– every step matters. For effective treatments, stem cell storage must adhere to Good Manufacturing Practice (GMP) certification and utilise ISO-class cleanrooms during processing. These processes and safety protocols ensure that the stem cells remain viable, contamination-free, and ready for clinical application when needed –immediately or after several years.
10 Myths about Stem Cells: Debunked!
Myth #1: Stem cell collection process is invasive and harmful
The Truth: Stem cell therapy is safe and does not harm the mother or her newborn.
- It is a safe and painless procedure that is performed post-delivery
- It carries zero risk to the mother and baby
- Stem cell collection can occur even with delayed cord clamping
- It does not interfere with the birthing process in any way
- It is collected only after the baby is delivered (either vaginally or via C-section)
Myth #2: Stem cell treatments are still experimental
The Truth: Stem cell treatments have been proven to treat 80+ life-threatening conditions.
- They have established treatments for conditions like leukaemia, thalassemia, immune system disorders, and several other blood-related conditions.
- At present, there have been over 40,000 successful transplants performed globally.
- While there is evidence-based clinical application today, there is future potential for stem cells in regenerative medicine.
Myth #3: Cord blood is beneficial only for the baby
The Truth: Banked stem cells not only benefit the child they came from but also other family members.
- While they are a 100% genetic match for the baby, they can be used to treat siblings, parents, parents’ siblings and grandparents.
- Family banking extends benefits to close relatives
- HLA compatibility for multiple family members
- Stem cell banking acts like a biological insurance for individuals and families.
Myth #4: All stem cell banks are the same
The Truth: This is not true! Quality and standards vary between facilities.
- Continually evaluate critical differences in accreditation standards (AABB, FACT, GMP certification) of stem cell banks.
- Processing technology and techniques vary significantly, often affecting the quality and cost
- Storage conditions and monitoring protocols differ at every bank
- Cell viability and recovery rates vary between facilities
- Laboratory expertise and certifications matter
When choosing a bank for your little one’s stem cells, here are a few things you must ensure the bank has:
- It is a GMP-certified facility
- It has ISO-class cleanrooms for stem cell isolation and cultivation
- It has advanced processing capabilities, including cultured mesenchymal stem cells
- Features an in-house molecular and genomic testing capability
- Ensures secure cryopreservation in liquid nitrogen at -196°C
Myth #5: Cord blood can only be collected from vaginal blood
The Truth: Stem cells are collected from the umbilical cord, which remains intact regardless of the type of birth– vaginal or C-section.
- Stem cell collection is possible in the case of both vaginal and cesarean births.
- The collection procedure remains the same, regardless of the type of delivery method.
- There is no difference in stem cell quality or quantity if the baby is delivered vaginally or via C-section
- Both planned and emergency C-sections can be accommodated.
Myth #6: You can only bank stem cells at birth
The Broader Truth: Missing banking at birth is not a lost opportunity forever!
- Birth is the optimal time for cord blood and cord tissue (the youngest, most potent cells)
- Cord blood/tissue opportunity is once-per-child at delivery
- However, other sources of stem cells exist, and include the bone marrow, peripheral blood, and other tissues (dental pulp, fat tissue, menstrual blood)
- Since umbilical cord stem cells are younger and easier to match than adult sources, cord blood is preferred as the best source.
- Families with multiple children have multiple opportunities.
Myth #7: Public and private stem cell banking are the same
The Truth: This is far from the truth. There is a significant difference between public and private stem cell banking.
- Family or private banking involves exclusive family ownership and use of the stem cells, with guaranteed access to a perfect genetic match for the child. It is stored for the family’s future medical needs.
- Public banking involves the donation of the cord blood samples for public transplant needs, benefiting others in need. There is no family ownership of the sample.
When picking a stem cell bank, you will also be presented with banking package options:
- Cord blood only packages
- Cord blood + cord tissue packages
- Comprehensive packages including placental tissues
- Advanced packages with cultured mesenchymal stem cells
All stem cell samples are cryopreserved in liquid nitrogen at -196°C.
Myth #8: Stem cells only treat blood-related diseases
The Truth: The applications of stem cell treatments are not limited to blood disorders.
Emerging clinical trials and research are assessing the potential use of stem cells sourced from cord blood in the treatment of neurological conditions, orthopaedic applications, cardiac repair, wound healing, diabetes treatment, and infertility research.
Myth #9: Stem cell banking is just a passing trend
The Truth: Cord transplant and the use of stem cell therapies have been going on since the late 1990s.
- The first cord blood transplant was performed in 1988, which establishes that this is not a new concept.
- Decades of proven clinical use and research
- In recent times, there has been an exponential growth in medical applications and research.
- Stem cell banking opens doors for advanced technologies–Precision medicine, genomic diagnostics.
- As science advances, more applications are being discovered
- Future of regenerative and personalised healthcare integrating biobanking, precision medicine, and genomic diagnostics
Myth #10: Stored stem cells don’t last beyond 20 years
The Truth: If stem cells are cryopreserved properly, they can remain viable indefinitely.
- Scientific studies demonstrate viability after 25+ years of storage
- Liquid nitrogen storage at -196°C essentially stops biological ageing
- No cellular degradation occurs during proper cryopreservation
- Controlled-rate cryopreservation ensures long-term cell integrity
- Reputable facilities offer guaranteed storage for 20-30 years with secure banking
When opting for banked stem cells, you will need to pick from a range of options. Here’s what can be banked:
- Cord blood: It is rich in Hematopoietic Stem Cells (HSCs), which help treat blood and immune disorders.
- Cord tissue: It is rich in Mesenchymal Stem Cells (MSCs) and is very helpful for regenerative medicine and tissue repair.
- Advanced Options:
-
- Cord vessel (MSCs)
- Placental tissues: Amniotic membrane, Chorionic, Decidua basalis (MSCs)
- Cultured mesenchymal stem cells (advanced processing)
Ask about package options, which range from basic cord blood-only to comprehensive packages including blood,
Making an Informed Decision: What Parents Should Know
Here are a few things to consider before opting for stem cell banking:
- Family medical history: If you have genetic conditions, cancer history, blood disorders, or autoimmune diseases in the family, stem cell banking may be a good investment to secure your family’s future.
- Understanding banking options: Assess and evaluate all factors (family, lifestyle and other risk factors) to determine which type of stem cell banking is best for your family.
- Deciding what to bank: Cord blood only vs. comprehensive packages is another dilemma that parents often face. When unsure or in doubt, feel free to consult with your doctor.
- When to decide: Ideally, during the second trimester for kit delivery and preparation
Quality Indicators to Look For in a Stem Cell Bank
Once you have decided on the type of stem cell bank you wish to pick, here are a few parameters that will help you assess its standard and quality:
- GMP/ISO certification and accreditation
- In-house processing capabilities (not outsourced)
- Transparent processing methods
- Laboratory expertise and certifications
- Storage security and monitoring protocols
The Collection and Storage Process
- Registration: Once parents are ready for stem cell banking, they must register with the chosen facility during pregnancy
- Kit Delivery: Collection kit delivered to the hospital or home before delivery
- Collection: Trained professionals perform post-delivery collection (5-10 minutes)
- Transportation: Specialised kit with controlled temperature (2-8°C), rapid delivery to the laboratory
- Laboratory Processing: The laboratory must be GMP-compliant ISO ISO-certified.
Here’s what happens in the laboratory:- Stem cells are isolated
- They are tested for cell count, viability, contamination analysis, and sterility tests
- Cryopreservation: Controlled-rate freezing and storage in liquid nitrogen at -196°C
Conclusion: The Bottom Line
Stem cell banking is a proven, safe, and increasingly valuable form of biological insurance for your family’s future health. Dispelling common myths allows parents to make informed, confident healthcare decisions. Choosing an accredited and certified facility is crucial to ensure the quality, safety, and long-term viability of the stored cells. When deciding, it’s also important to consider your family’s medical history and future healthcare needs.
FAQs
1. When should I decide about stem cell banking?
Ideally, in the 2nd trimester, but you can also decide in your third trimester.
2. Can I bank stem cells if I have a C-section?
Stem cells can be collected safely after a vaginal (normal) delivery or a C-section.
3. How long does the collection process take?
Stem cell collection from cord blood is a quick procedure and takes 5 to 10 minutes.
4. What’s the difference between cord blood and cord tissue banking?
While cord blood contains haemopoietic stem cells that are used to treat blood disorders, cord tissue contains mesenchymal stem cells with the potential of regeneration into other tissues like muscles, bones and nerves.
5. Are there any risks to my baby or me during the collection?
The collection of cord blood happens after the birth of the child and therefore poses no risk to the mother or baby.
6. How do I know stem cells will remain viable for years?
Reputed stem cell banks that are certified and accredited follow global standards of cryopreservation of stem cells, ensuring their long-term viability.
7. Can my other children use the banked stem cells?
Possibly. Siblings have up to a 75% chance of being a suitable match, depending on genetic compatibility.
8. What should I look for when choosing a stem cell bank?
Check for GMP certification, ISO-class labs, accreditations, transparent processes, and strong track records in successful transplants.
9. How are stem cells currently being used in medical treatments?
Cord blood stem cells treat 80+ diseases such as leukaemia. Ongoing research explores regenerative therapies for diabetes, heart disease, and neurological conditions.
 Stem Cell Banking
Stem Cell Banking Cord Blood & Tissue
Cord Blood & Tissue

Non-Invasive Prenatal Testing/Screening
Non-Invasive Prenatal Testing/Screening Pre-Implantation Genetic Testing/Screening (PGT/PGS)
Pre-Implantation Genetic Testing/Screening (PGT/PGS) Male/Female Fertility
Male/Female Fertility Rapid Prenatal & Pregnancy Loss
Rapid Prenatal & Pregnancy Loss Maternal Cell Contamination (MCC)
Maternal Cell Contamination (MCC) Product of Conception (POC)
Product of Conception (POC) My HLA (Human Leucocyte Antigen)
My HLA (Human Leucocyte Antigen) Whole Genome Sequencing (WGS)
Whole Genome Sequencing (WGS) Whole Exome Sequencing (WES)
Whole Exome Sequencing (WES) Low Pass Sequencing (1-3x Coverage)
Low Pass Sequencing (1-3x Coverage) Comprehensive Oncology Screening
Comprehensive Oncology Screening Breast Cancer Screening (BRCA)
Breast Cancer Screening (BRCA) Cervical Cancer Screening
Cervical Cancer Screening Prostate Cancer Screening
Prostate Cancer Screening Heredity Cancer Panel
Heredity Cancer Panel Leukemia Panel
Leukemia Panel Lymphoma Panel
Lymphoma Panel Carrier Screening
Carrier Screening Newborn Screening
Newborn Screening Infectious Diseases Screening
Infectious Diseases Screening Rare Diseases Screening
Rare Diseases Screening Consumer Genomics
Consumer Genomics Gut Metagenomics
Gut Metagenomics Metagenomics
Metagenomics Personalized Medicine
Personalized Medicine